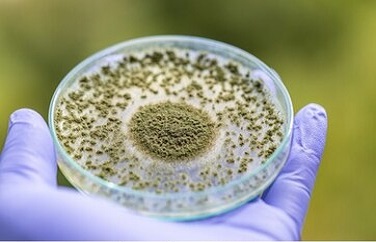

-

玉米赤霉烯酮分析儀,操作簡便結(jié)果定量
微測生物玉米赤霉烯酮分析儀-FD600玉米赤霉烯酮檢測儀檢測結(jié)果準(zhǔn)確可靠,基于熒光定量快速檢測系統(tǒng),包括玉米赤霉烯酮熒光定量快速檢測卡、熒光定量快速檢測儀,可快速測定儀玉米、玉米粕等玉米相關(guān)副產(chǎn)品中玉米赤霉烯酮的含量。
Time:2021-05-13在線閱讀 -

玉米赤霉烯酮檢測儀,檢測結(jié)果可溯源
南京微測玉米赤霉烯酮檢測儀應(yīng)用熒光定量快速檢測原理,可快速定量檢測糧食、谷物、飼料等樣本中玉米赤霉烯酮的含量。
Time:2021-05-13在線閱讀 -

玉米赤霉烯酮檢測儀,定量檢測
玉米赤霉烯酮檢測儀【南京微測生物FD-600】通過熒光定量快速檢測技術(shù),檢測結(jié)果高度符合國標(biāo)法HPLC-MS法,快速準(zhǔn)確定量分析待測樣本中玉米赤霉烯酮含量。玉米赤霉烯酮檢測儀適用于糧食檢測行業(yè)、糧食飼料加工廠、食品加工貿(mào)易、市場監(jiān)管部門等。
Time:2021-05-13在線閱讀 -

赭曲霉毒素A檢測儀,快速定量檢測
赭曲霉毒素A檢測儀【南京微測FD-600】小巧便攜,隨到隨檢,安全環(huán)保,快速簡便,準(zhǔn)確定量,經(jīng)濟實惠,聯(lián)網(wǎng)溯源,赭曲霉毒素A專業(yè)檢測儀器。
Time:2021-05-13在線閱讀 -

赭曲霉毒素檢測儀,檢測結(jié)果可溯源
赭曲霉毒素檢測儀是當(dāng)前赭曲霉毒素A檢測分析的必備設(shè)備,采用熒光定量檢測原理,配合赭曲霉毒素快速檢測卡,可快速準(zhǔn)確定量測定糧食谷物、飼料原料及成品飼料中赭曲霉毒素的含量。
Time:2021-05-13在線閱讀 -
赭曲霉毒素A快速檢測儀,精度高重復(fù)性好
赭曲霉毒素A快速檢測儀【南京微測生物FD-600】可檢測樣品包括糧食谷物及其制品、飼料及原料,樣品前處理簡單,操作快速簡便,結(jié)果準(zhǔn)確定量。
Time:2021-05-13在線閱讀 -

真菌毒素檢測儀-真菌毒素快速檢測儀
真菌毒素檢測儀|真菌毒素快速檢測儀是南京微測生物科技有限公司生產(chǎn)的真菌毒素快速檢測分析設(shè)備。
Time:2021-05-11在線閱讀 -

糧食真菌毒素檢測儀-糧食真菌毒素快速檢測儀-真菌毒素定量分析儀
南京微測糧食真菌毒素檢測儀-糧食真菌毒素快速檢測儀-真菌毒素定量分析儀,采用熒光定量快速檢測原理,通過儀器內(nèi)置的標(biāo)準(zhǔn)曲線即可計算出樣品中真菌毒素的含量并根據(jù)參考值判斷陰陽性。
Time:2021-05-11在線閱讀

